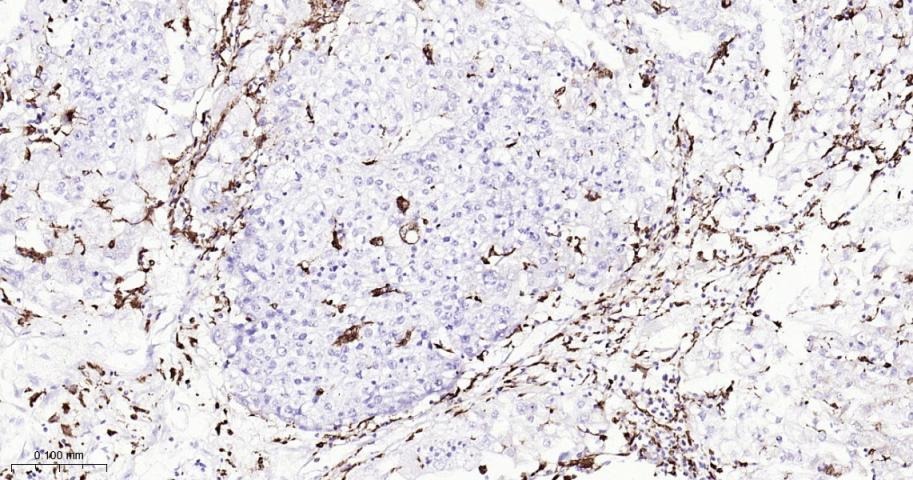

购物车
 您的购物车当前为空
您的购物车当前为空
Anti-CD68 Antibody (2P747) 是一种 Rabbit 抗体,靶向 CD68。Anti-CD68 Antibody (2P747) 可用于 FCM, IF, IHC-Fr, IHC-P。
别名 SCARD1, LAMP4, GP110, CD68 molecule
Anti-CD68 Antibody (2P747) 是一种 Rabbit 抗体,靶向 CD68。Anti-CD68 Antibody (2P747) 可用于 FCM, IF, IHC-Fr, IHC-P。
| 规格 | 价格 | 库存 | 数量 |
|---|---|---|---|
| 25 μL | ¥ 785 | 5日内发货 | |
| 50 μL | ¥ 1,395 | 5日内发货 | |
| 100 μL | ¥ 2,495 | 5日内发货 |
TargetMol的所有产品仅用作科学研究或药证申报,不能被用于人体,我们不向个人提供产品和服务。请您遵守承诺用途,不得违反法律法规规定用于任何其他用途。
| 产品描述 | Anti-CD68 Antibody (2P747) is a Rabbit antibody targeting CD68. Anti-CD68 Antibody (2P747) can be used in FCM, IF, IHC-Fr, IHC-P. |
| 别名 | SCARD1, LAMP4, GP110, CD68 molecule |
| Ig Type | IgG |
| 克隆号 | 2P747 |
| 反应种属 | Human |
| 验证活性 | 1. Paraformaldehyde-fixed, paraffin embedded (human tonsil); Antigen retrieval by boiling in sodium citrate buffer (pH6.0) for 15 min; Block endogenous peroxidase by 3% hydrogen peroxide for 20 min; Blocking buffer (normal goat serum) at 37°C for 30 min; Antibody incubation with (CD68) Monoclonal Antibody, Unconjugated (TMAB-00384) at 1:200 overnight at 4°C, followed by operating according to SP Kit (Rabbit) instructionsand DAB staining. 2. Paraformaldehyde-fixed, paraffin embedded (human cervical carcinoma); Antigen retrieval by boiling in sodium citrate buffer (pH6.0) for 15 min; Block endogenous peroxidase by 3% hydrogen peroxide for 20 min; Blocking buffer (normal goat serum) at 37°C for 30 min; Antibody incubation with (CD68) Monoclonal Antibody, Unconjugated (TMAB-00384) at 1:200 overnight at 4°C, followed by operating according to SP Kit (Rabbit) instructionsand DAB staining. 3. Paraformaldehyde-fixed, paraffin embedded (human liver); Antigen retrieval by boiling in sodium citrate buffer (pH6.0) for 15 min; Block endogenous peroxidase by 3% hydrogen peroxide for 20 min; Blocking buffer (normal goat serum) at 37°C for 30 min; Antibody incubation with (CD68) Monoclonal Antibody, Unconjugated (TMAB-00384) at 1:200 overnight at 4°C, followed by operating according to SP Kit (Rabbit) instructionsand DAB staining. 4. Paraformaldehyde-fixed, paraffin embedded (human lung carcinoma); Antigen retrieval by boiling in sodium citrate buffer (pH6.0) for 15 min; Block endogenous peroxidase by 3% hydrogen peroxide for 20 min; Blocking buffer (normal goat serum) at 37°C for 30 min; Antibody incubation with (CD68) Monoclonal Antibody, Unconjugated (TMAB-00384) at 1:200 overnight at 4°C, followed by operating according to SP Kit (Rabbit) instructionsand DAB staining. 5. Paraformaldehyde-fixed, paraffin embedded (human endometrial carcinoma); Antigen retrieval by boiling in sodium citrate buffer (pH6.0) for 15 min; Block endogenous peroxidase by 3% hydrogen peroxide for 20 min; Blocking buffer (normal goat serum) at 37°C for 30 min; Antibody incubation with (CD68) Monoclonal Antibody, Unconjugated (TMAB-00384) at 1:200 overnight at 4°C, followed by operating according to SP Kit (Rabbit) instructionsand DAB staining. 6. Blank control: THP-1. Primary Antibody (green line): Rabbit Anti-CD68 antibody (TMAB-00384) Dilution: 1 μg/Test; Secondary Antibody (white blue line): Goat anti-rabbit IgG-AF488 Dilution: 0.5 μg/Test. Isotype control (orange line): Normal Rabbit IgG Protocol The cells were incubated in 5% BSA to block non-specific protein-protein interactions for 30 min at room temperature. Cells stained with Primary Antibody for 30 min at room temperature. The secondary antibody used for 40 min at room temperature. 7. 4% Paraformaldehyde-fixed THP-1 (H) cell; Triton X-100 at RT for 20 min; Antibody incubation with (CD68) monoclonal Antibody, unconjugated (TMAB-00384) 1:100, 90 min at 37°C; followed by conjugated Goat Anti-Rabbit IgG antibody (green) at 37°C for 90 min, DAPI (blue) was used to stain the cell nucleus. |
| 应用 | FCMIFIHC-FrIHC-P |
| 推荐剂量 | FCM=1 μg/Test; IF=1:500-1000; IHC-Fr=1:500-1000; IHC-P=1:500-1000 |
| 抗体种类 | Monoclonal |
| 宿主来源 | Rabbit |
| 亚细胞定位 | Isoform Short: Cell membrane; Single-pass type I membrane protein. Isoform Long: Endosome membrane; Single-pass type I membrane protein. Lysosome membrane; Single-pass type I membrane protein. |
| 组织特异性 | Highly expressed by blood monocytes and tissue macrophages. Also expressed in lymphocytes, fibroblasts and endothelial cells. Expressed in many tumor cell lines which could allow them to attach to selectins on vascular endothelium, facilitating their diss |
| 构建方式 | Recombinant Antibody |
| 纯化方式 | Protein A purified |
| 性状 | Liquid |
| 缓冲液 | 0.01M TBS (pH7.4) with 1% BSA, 0.02% Proclin300 and 50% Glycerol. |
| 浓度 | 1 mg/mL |
| 研究背景 | This gene encodes a 110-kD transmembrane glycoprotein that is highly expressed by human monocytes and tissue macrophages. It is a member of the lysosomal/endosomal-associated membrane glycoprotein (LAMP) family. The protein primarily localizes to lysosomes and endosomes with a smaller fraction circulating to the cell surface. It is a type I integral membrane protein with a heavily glycosylated extracellular domain and binds to tissue- and organ-specific lectins or selectins. The protein is also a member of the scavenger receptor family. Scavenger receptors typically function to clear cellular debris, promote phagocytosis, and mediate the recruitment and activation of macrophages. Alternative splicing results in multiple transcripts encoding different isoforms. [provided by RefSeq, Jul 2008] |
| 免疫原 | KLH conjugated synthetic peptide: human CD68 |
| 抗原种属 | Human |
| 基因名称 | CD68 |
| 基因ID | |
| 蛋白名称 | Macrosialin |
| Uniprot ID | |
| 研究领域 | Myeloid Cells,SARS Coronavirus |
| 功能 | Could play a role in phagocytic activities of tissue macrophages, both in intracellular lysosomal metabolism and extracellular cell-cell and cell-pathogen interactions. Binds to tissue- and organ-specific lectins or selectins, allowing homing of macrophage subsets to particular sites. Rapid recirculation of CD68 from endosomes and lysosomes to the plasma membrane may allow macrophages to crawl over selectin-bearing substrates or other cells. |
| 分子量 | Theoretical: 37 kDa. |
| 储存方式 | Store at -20°C or -80°C for 12 months. Avoid repeated freeze-thaw cycles. |
| 运输方式 | Shipping with blue ice. |